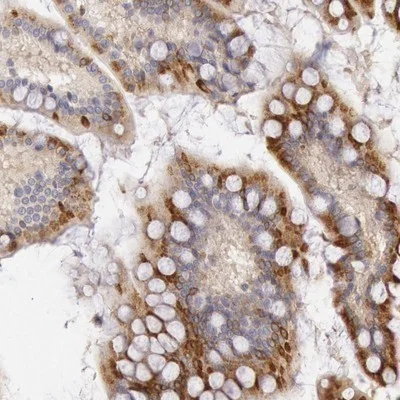
PLA2G6-Antibody-Immunohistochemistry-Paraffin-NBP1-81586-img0002.jpg

We focus on Parkinson Disease & Infantile Neuroaxonal Dystrophy
Parkinson's disease (PD)
Our current research focuses on:
Alpha Synuclein
The accumulation of aggregated alpha-synuclein within Lewy bodies and Lewy neurites is the defining feature of idiopathic PD.
Imaging Agents
An alpha-synuclein imaging agent would improve the diagnosis of Parkinson disease and could be used to monitor the effectiveness of disease-modifying treatments.
Loss of Connections
The relationship between the loss of neuronal connections and non-motor PD symptoms could result in better treatments.
Treatments
Developing treatments that slow or stop the accumulation of alpha-synuclein fibrils in the brain could slow or stop the progression of Parkinson Disease.
Infantile Neuroaxonal Dystrophy (INAD)
Our current research focuses on:
Enzyme Function
Investigating the ways in which mutations responsible for INAD and PKAN affect the function of the enzymes encoded by the PLA2G6 and PANK2 genes.
Treatments
Developing treatments that improve the function of enzymes affected by disease-causing mutations and that compensate for the loss of enzyme function.
Dr. Kotzbauer also sees patients in the Movement Disorders Center at Washington University School of Medicine.
To contact the Movement Disorders Center click here.